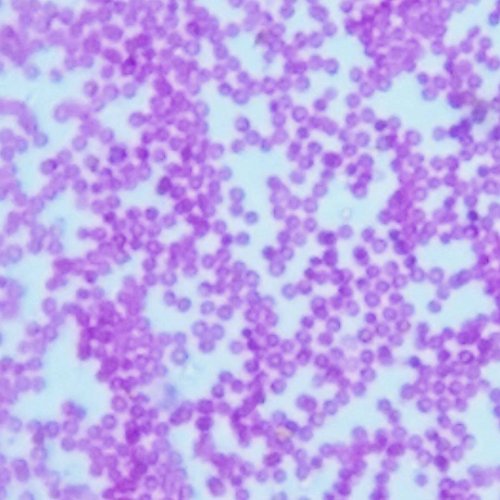
Blips Ultra Labkit - Kit da tavolo per trasformare lo smartphone in microscopio

#Blips #Ultra #Labkit #tavolo #trasformare #smartphone #microscopio Blips Ultra Labkit - Kit da tavolo per trasformare lo smartphone in microscopio

<
Brand : blips magnify the worldBinding : ElettronicaColor : EAN : 8388765862586Label : Smartmicrooptics srlProduct Group : FotografiaProduct Type Name : MICROSCOPESManufacturer : Smartmicrooptics srl
Feature :
- banda adesiva di ricambio (adesivo attacca-stacca, per 10 sostituzioni) - app gratuita (compatibile con iOS, Android e Windows Phone)
- 1 stage di supporto per lo smartphone
- 1 sorgente luminosa led bianco
- 6 vetrini preparati per microscopio
- kit di 3 lenti Blips (Macro, Micro e Ultra) per smartphone

Blips Ultra Labkit - Kit da tavolo per trasformare lo smartphone in microscopio. Un kit completo per trasformare ogni tipo di smartphone e tablet in un potente microscopio digitale in luce trasmessa. Il kit comprende 3 lenti Blips, le più sottili lenti al mondo per la microscopia da smartphone, per 3 diversi livelli di ingrandimento. Grazie all'app dedicata (scaricabile gratuitamente) è possibile realizzare foto e video del micromondo. Made in Italy #Blips #Ultra #Labkit #tavolo #trasformare #smartphone #microscopio